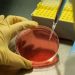
Fund for struggling biotechs takes aim at ‘tragedy’ for shareholders

Welcome to Power Supply, coming to you from New York.
Federal Reserve chair Jay Powell stated Donald Trump’s tariffs may cause higher inflation and slower growth, complicating the US central financial institution’s endeavour to tame inflation with tight financial coverage.
Fears over greater inflation and slower development on this planet’s largest financial system have precipitated oil markets to stay risky. Goldman Sachs, HSBC and JPMorgan have all trimmed oil worth forecasts for this 12 months and subsequent.
As BP and Shell have lower their funding in renewable power, my colleagues Ian Johnston and Tom Wilson report that TotalEnergies has avoided its rivals’ fate. The French group has constantly elevated oil and gasoline manufacturing by 3 per cent annually whereas investing $4bn yearly in its built-in energy division, which focuses on producing and supplying electrical energy by way of wind farms, photo voltaic farms and gas-fired energy stations.
My colleague Amanda Chu reported that the US has halted a $5bn offshore wind project that Norway’s Equinor is creating. The Trump administration’s transfer alerts an aggressive new push in opposition to clear power initiatives. However not all renewable power sources are handled equally.
In right now’s Power Supply we take a better take a look at geothermal, a renewable power useful resource that has been quietly gaining traction because it has garnered assist from Huge Tech as a promising technique to energy information centres. Regardless of the Trump administration’s scepticism surrounding the clear power business — notably wind and photo voltaic — they’ve championed geothermal.
Thanks for studying, Alexandra
Geothermal: the Trump administration’s renewable power darling
As Donald Trump pursues his “drill, child, drill” agenda, one renewable power supply might unexpectedly profit from his pro-fossil fuels stance.
Geothermal power, which makes use of the earth’s warmth to create electrical energy, is quietly gaining recognition within the US as new technological developments could possibly scale this carbon-free, around-the-clock energy supply.
Conventional geothermal vegetation, which generate electrical energy by transferring fluid alongside scorching rocks, have to be positioned close to pure reservoirs of scorching water that exist beneath the earth’s floor. However advances within the know-how can utilise strategies from the oil and gasoline business to drill wells that may generate power from man-made reservoirs that may be positioned anyplace.
“The identical skillsets which might be used for oil and gasoline drilling are what permits for subsequent era geothermal to maneuver ahead,” stated Drew Nelson, vice-president of programmes, coverage and technique at Venture InnerSpace, a non-profit targeted on advancing the geothermal business.
Subsequent-generation geothermal has already attracted assist from large know-how firms, together with Google, that are searching for clear power for his or her information centres. It additionally has the assist of the White Home. Power secretary Chris Wright was an investor in geothermal start-up Fervo Power and named the ability supply as an space of curiosity throughout his affirmation listening to.
Whereas final 12 months might have been nuclear’s time to shine, some analysts imagine geothermal power may steal the highlight in 2025 because it advantages from assist from the Trump administration and Huge Tech.
Google has already partnered with Fervo Power to produce energy to its information centres in Nevada. One other geothermal start-up, Sage Geosystems, has agreed to produce Meta with 150MW of capability to energy its information centres beginning in 2027.
“The necessity for energy from the AI sector has solely elevated the curiosity general in geothermal,” stated Cindy Taff, chief govt of Sage Geosystems, including that there had been “important curiosity” from different hyperscalers within the power supply.
The Worldwide Power Company reported that geothermal meets lower than 1 per cent of worldwide power demand however with continued mission price reductions and technological enhancements, it estimates that it may meet as much as 15 per cent of worldwide electrical energy demand development to 2050.
Geothermal additionally suits with the Trump administration’s mantra of “drill child drill”, as it could leverage fracking and drilling expertise from the oil and gasoline business. Wooden Mackenzie estimates that if geothermal is to develop from 50GW to over 250GW by 2050, the business must drill 35,000 new wells.
Regardless of the joy, consultants warn that the know-how nonetheless has a protracted approach to go.
The Division of Power stated in a report final 12 months that it expects “business lift-off” to be attainable as early as 2030 however provided that it “can obtain a set of market circumstances round price, demonstrations, worth and neighborhood engagement”.
Richard Hood, senior analysis supervisor at Wooden Mackenzie’s subsurface crew, stated that lots of the next-generation geothermal initiatives are largely pilot initiatives which have but to be confirmed at full business scale.
It’s also very costly to drill. Gregory Keoleian, director on the College of Michigan Faculty for Atmosphere and Sustainability, stated that in sure areas of the US, scorching rock that isn’t near the floor will power producers to drill deeper — an more and more costly endeavour.
Wooden Mackenzie estimates geothermal’s present levelised price of electrical energy to be between $100/MWh to $200/MWh, which is far greater than its estimate for large-scale nuclear energy vegetation which might be estimated to vary between $75/MWh to $100/MWh.
“There’s an enormous nuclear drive in America that’s working parallel to this geothermal drive, however nuclear is much extra established and is seen as cheaper,” Hood stated.
Nonetheless, because the know-how turns into extra superior it’s prone to drive down prices. Final 12 months, Fervo Power introduced it had proven a 70 per cent year-over-year discount in drilling instances for its Cape Station mission that has translated into prices falling from $9.4mn to $4.8mn per properly.
“We’re already seeing prices come down as extra oil and gasoline experience is introduced into the sector,” Venture InnerSpace’s Nelson stated. “The know-how will likely be improved as increasingly initiatives stand up off the bottom.” (Alexandra White)
Job strikes
-
enCore Power has appointed Nathan Tewalt to its board of administrators.
-
John Donaleski has joined White & Case as a associate in its international mission improvement and finance follow and international power business group.
-
Petronet LNG has named Saurav Mitra as director of finance and chief monetary officer.
-
Kaveh Rouhi has been appointed chief monetary officer of SMA Photo voltaic.
Energy Factors
-
The European Fee is learning legal options that may enable firms to interrupt long-term Russian gasoline contracts with out penalties.
-
The UK regulator says British households may face totally different electricity rates relying on their revenue.
-
The Malian authorities has threatened to grab management of Barrick Gold’s belongings within the nation as tensions between the Canadian mining firm and the navy junta rise.
Power Supply is written and edited by Jamie Smyth, Myles McCormick, Amanda Chu, Tom Wilson and Malcolm Moore, with assist from the FT’s international crew of reporters. Attain us at energy.source@ft.com and observe us on X at @FTEnergy. Compensate for previous editions of the e-newsletter here.
Beneficial newsletters for you
Ethical Cash — Our unmissable e-newsletter on socially accountable enterprise, sustainable finance and extra. Sign up here
The Local weather Graphic: Defined — Understanding crucial local weather information of the week. Join here